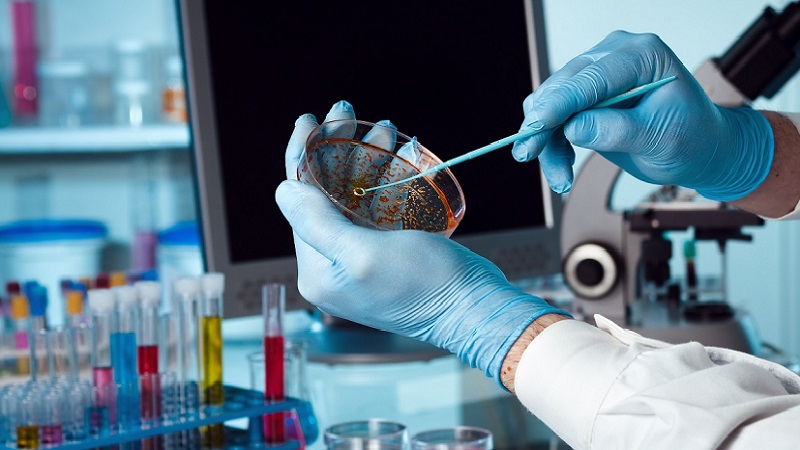

মাহবুবুর রহমান/ মাসুদ রানা:
বাংলাদেশের স্বাস্থ্যসেবা খাত দিন দিন উন্নতির দিকে এগোলেও এখনো অনেক ক্ষেত্রে অপূর্ণতা রয়ে গেছে। এর একটি গুরুত্বপূর্ণ দিক হলো বায়োকেমিস্টদের অবদান যথাযথভাবে মূল্যায়ন না করা।
রোগ নির্ণয় এবং সঠিক চিকিৎসার ভিত্তি যে পরীক্ষাগার বা ডায়াগনস্টিক রিপোর্ট, তা বায়োকেমিস্টদের হাত ধরেই বাস্তবায়িত হয়। তা সত্ত্বেও, এই পেশাজীবীদের ভূমিকা সরকারিভাবে অবহেলিত থেকে যাচ্ছে।
বায়োকেমিস্টদের অবদান; রোগ নির্ণয়ের মূল ভিত্তি: একজন বায়োকেমিস্ট রোগ নির্ণয়ে পরীক্ষাগারের গুণগত মান নিশ্চিত করার মূল দায়িত্ব পালন করেন। পরীক্ষাগারে ব্যবহৃত যন্ত্রপাতি পরিচালনা, মান নিয়ন্ত্রণ, পরীক্ষার সঠিকতা যাচাই এবং রোগ নির্ণয়ের জন্য রিপোর্ট প্রস্তুত করাই তাদের কাজ।
বিশ্বের উন্নত স্বাস্থ্য ব্যবস্থার দেশগুলোতে বায়োকেমিস্টদের গুরুত্ব অপরিসীম। সেখানে তাদের স্বীকৃতি শুধু প্রয়োজনীয়ই নয়, বাধ্যতামূলক। বাংলাদেশেও আইসিডিডিআরবি, বারডেম বা বিএসএমএমইউর মতো প্রতিষ্ঠানে বায়োকেমিস্টদের অবদান দীর্ঘদিন ধরে প্রশংসিত। তবে সরকারের বিভিন্ন নীতিমালায় তাদের সিগনেটরি অথরিটি (রিপোর্টে স্বাক্ষর করার ক্ষমতা) অগ্রাহ্য করা হচ্ছে, যা তাদের দক্ষতা ও পেশাগত গুরুত্বকে অবমাননা করছে।
স্বাস্থ্য খাতের চ্যালেঞ্জ ও বায়োকেমিস্টদের অভাব: স্বাস্থ্য অধিদপ্তরের তথ্য অনুসারে দেশে ১০ হাজারেরও বেশি ডায়াগনস্টিক সেন্টার রয়েছে। কিন্তু সরকারি হাসপাতালগুলোতে বায়োকেমিস্টদের নিয়োগ অত্যন্ত সীমিত। জেলা ও উপজেলা পর্যায়ে তাদের কোনো অবস্থান নেই, যেখানে প্রাথমিক স্বাস্থ্যসেবার চাহিদা সবচেয়ে বেশি।
এর ফলে, অনভিজ্ঞ টেকনিশিয়ানদের ওপর নির্ভর করতে হচ্ছে, যা পরীক্ষার মানের ওপর নেতিবাচক প্রভাব ফেলছে। অনেক ল্যাবরেটরি মানহীন যন্ত্রপাতি ও মেয়াদোত্তীর্ণ রিএজেন্ট ব্যবহার করে, যা রোগ নির্ণয়ে ভুল ফলাফল দিচ্ছে। এর ফলে রোগীদের বিদেশমুখিতা বৃদ্ধি পাচ্ছে।
বায়োকেমিস্টদের অবদান কোভিড মহামারিতে: কোভিড-১৯ মহামারির সময় বায়োকেমিস্টদের ভূমিকা ছিল অসামান্য। পিসিআর মেশিন পরিচালনা থেকে শুরু করে টেস্ট প্রটোকল তৈরি এবং প্রশিক্ষণ প্রদানের মাধ্যমে তারা সারা দেশে কোভিড পরীক্ষার সেবা নিশ্চিত করেন। অথচ তাদের এই অবদানও নীতিনির্ধারকদের যথাযথ দৃষ্টিগোচর হয়নি।
বায়োকেমিস্টদের স্বীকৃতি ও সরকারের নীতিমালা: স্বাস্থ্যসেবা ও সুরক্ষা আইন ২০২৪ এর ৯ নম্বর ধারার ৪ নম্বর উপধারা বায়োকেমিস্টদের অবদানকে উপেক্ষা করেছে। এতে ল্যাবরেটরি রিপোর্টে শুধু চিকিৎসকদের স্বাক্ষরের শর্ত আরোপ করা হয়েছে। এ ধরনের বৈষম্যমূলক নীতি শুধু অযৌক্তিকই নয়, বরং দেশের স্বাস্থ্য খাতের উন্নয়নে বাধা সৃষ্টি করবে।
যা করা প্রয়োজন:
১. সকল ল্যাবরেটরিতে বায়োকেমিস্টদের নিয়োগ বাধ্যতামূলক করা: সরকারি ও বেসরকারি উভয় পর্যায়ে দক্ষ বায়োকেমিস্টদের অন্তর্ভুক্তি নিশ্চিত করতে হবে।
২. আন্তর্জাতিক মানের প্রশিক্ষণ ও অ্যাক্রেডিটেশন: ল্যাবরেটরির মান উন্নত করতে আইএসও ১৫১৮৯-এর মতো আন্তর্জাতিক মানদণ্ড অনুযায়ী অ্যাক্রেডিটেশন বাধ্যতামূলক করা উচিত।
৩. বৈষম্যমূলক নীতি সংশোধন: স্বাস্থ্য সুরক্ষা আইন থেকে বায়োকেমিস্টদের প্রতি বৈষম্যমূলক ধারা বাদ দিয়ে তাদের স্বাক্ষরের অধিকার প্রদান করতে হবে।
৪. ল্যাবরেটরি মান নিয়ন্ত্রণ ব্যবস্থার উন্নয়ন: নিয়মিত অভ্যন্তরীণ ও বাহ্যিক মান নিয়ন্ত্রণ নিশ্চিত করতে হবে।
বাংলাদেশের স্বাস্থ্য খাতের উন্নয়ন নিশ্চিত করতে বায়োকেমিস্টদের অবদানকে যথাযথ মূল্যায়ন করা জরুরি। শুধু চিকিৎসকদের ওপর নির্ভরশীলতা কমিয়ে তাদের সঙ্গে বায়োকেমিস্টদের সমন্বিতভাবে কাজ করার সুযোগ তৈরি করতে হবে। এক্ষেত্রে সরকার ও নীতিনির্ধারকদের উদ্যোগ অত্যন্ত গুরুত্বপূর্ণ। দেশের স্বাস্থ্য খাতের টেকসই উন্নয়ন তখনই সম্ভব, যখন বায়োকেমিস্টদের যথাযথ মর্যাদা ও দায়িত্ব প্রদান করা হবে।
লেখক: লেখকদ্বয় বায়োকেমিস্ট
(এই বিভাগে প্রকাশিত মতামত লেখকের নিজস্ব। চ্যানেল আই অনলাইন এবং চ্যানেল আই-এর সম্পাদকীয় নীতির সঙ্গে প্রকাশিত মতামত সামঞ্জস্যপূর্ণ নাও হতে পারে।)








